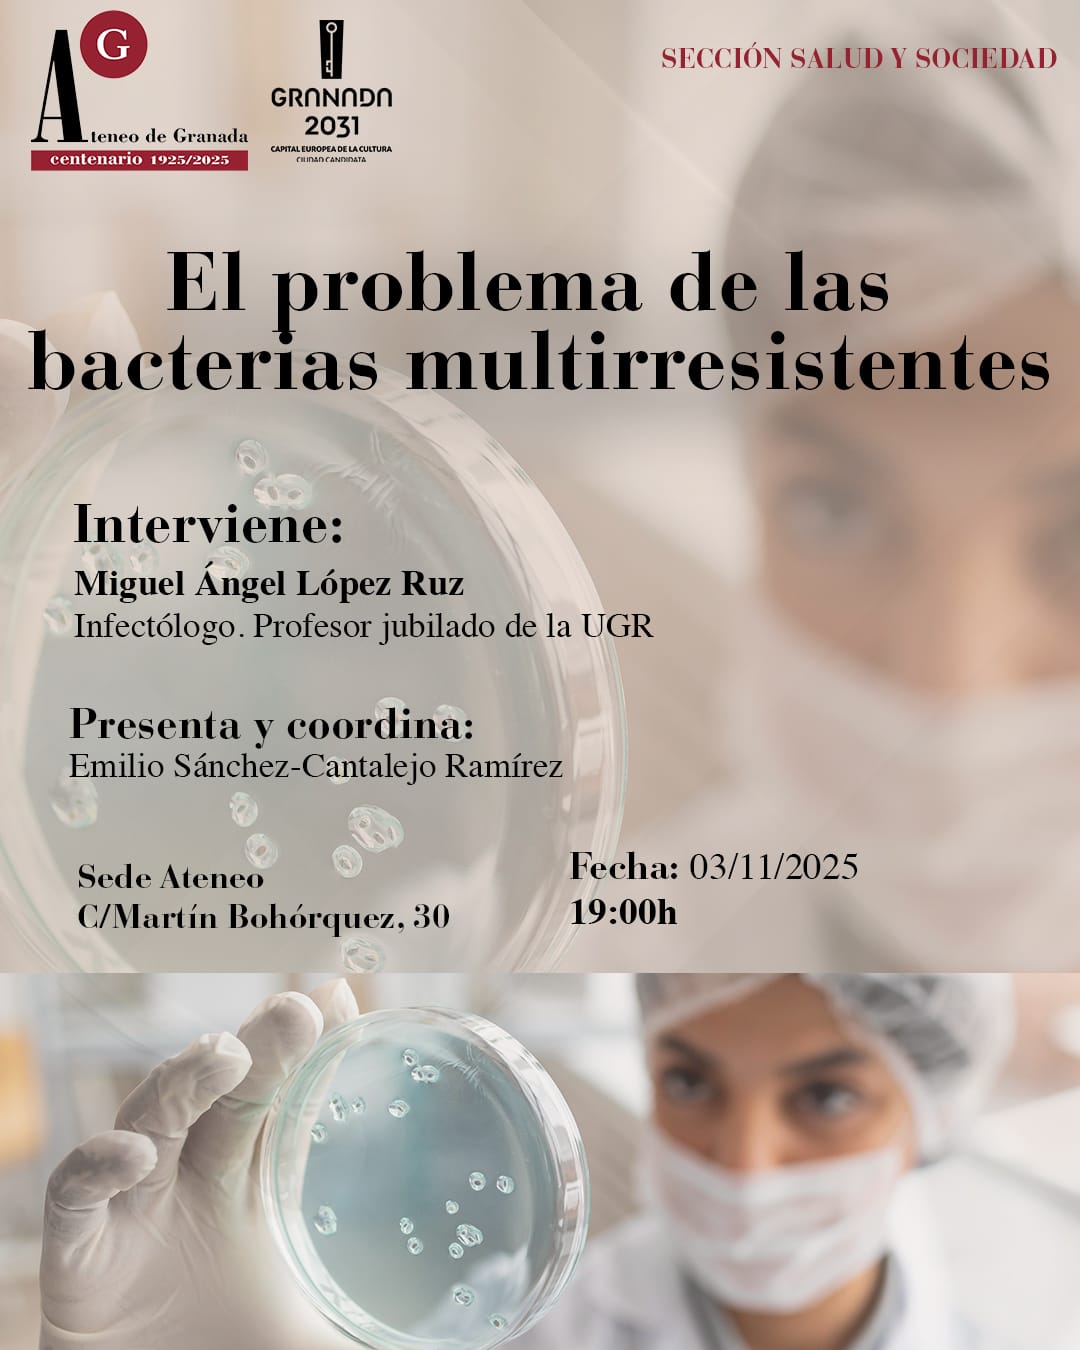

Ciclo Personalidades del Ateneo: El legado de Manuel de Falla
🎶 El legado de Manuel de Falla y su vínculo con el Ateneo de Granada 📌 Ciclo: Personalidades del Ateneo 📅 Miércoles, 29 de octubre de 2025 🕖 19:00 h […]


🎶 El legado de Manuel de Falla y su vínculo con el Ateneo de Granada 📌 Ciclo: Personalidades del Ateneo 📅 Miércoles, 29 de octubre de 2025 🕖 19:00 h […]

⚖️ Responsabilidad política y responsabilidad penal 📌 Sección Derecho y Sociedad del Ateneo de Granada y Sociedad Fabiana Española 📅 Jueves, 30 de octubre de 2025 🕕 18:00 h 📍 […]
🦠 El problema de las bacterias multirresistentes El próximo lunes 3 de noviembre a las 19:00 h, el Ateneo de Granada acoge una nueva conferencia dentro de la Sección Salud […]
Funciona con WordPress & Tema de Anders Norén